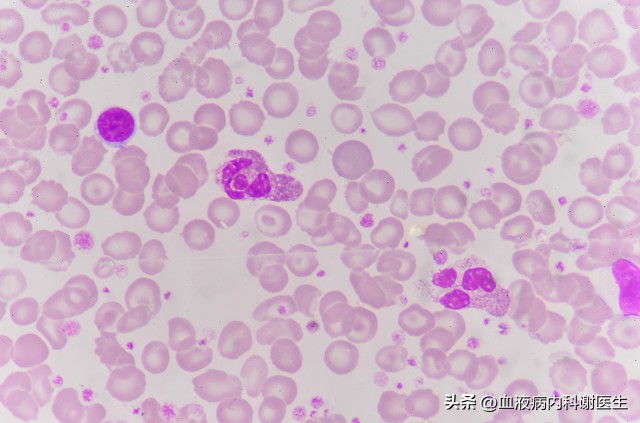
白细胞减少红细胞增多有什么危害,减少白细胞的方法

白细胞,又称白血球,是人体内的一种有核血细胞。它具有吞噬异物并产生抗体的作用,同时,在人体内发生感染时,它还能抵御病原体的入侵,为我们的身体提供抗体。

正常情况下,人体内血细胞的数目应该在4000-10000这一区间之内浮动,白细胞的数目十分容易受到外界情况的影响而变化。例如,当我们身体中每微升血液中白细胞超过10000时,就有可能是身体出现炎症导致的白细胞增多。相反,如果少于4000每微升,就是白细胞减少症,导致这一症状出现的原因则十分复杂,药物,感染,辐射,毒素摄入均会导致白细胞减少。
白细胞减少的典型症状包括困乏疲倦,觉多睡不醒,四肢酸痛以及反复地感冒发烧。
不管出于何种原因,一旦患上白细胞减少的疾病,就会出现头晕心悸,失眠乏力的症状,还会偶发咽喉及口腔黏膜出血,严重患者可能会导致皮肤干燥,头发枯槁,关节疼痛,肝脾肿大,同时肌肤也会常见出血点以及青紫色血瘀斑。

如果怀疑自身出现的与上文相符合的症状属于白细胞减少症,可以去医院进行血常规或是骨髓检查,也可以通过病毒学检查或是免疫学检查等来确诊是否属于白细胞减少。
